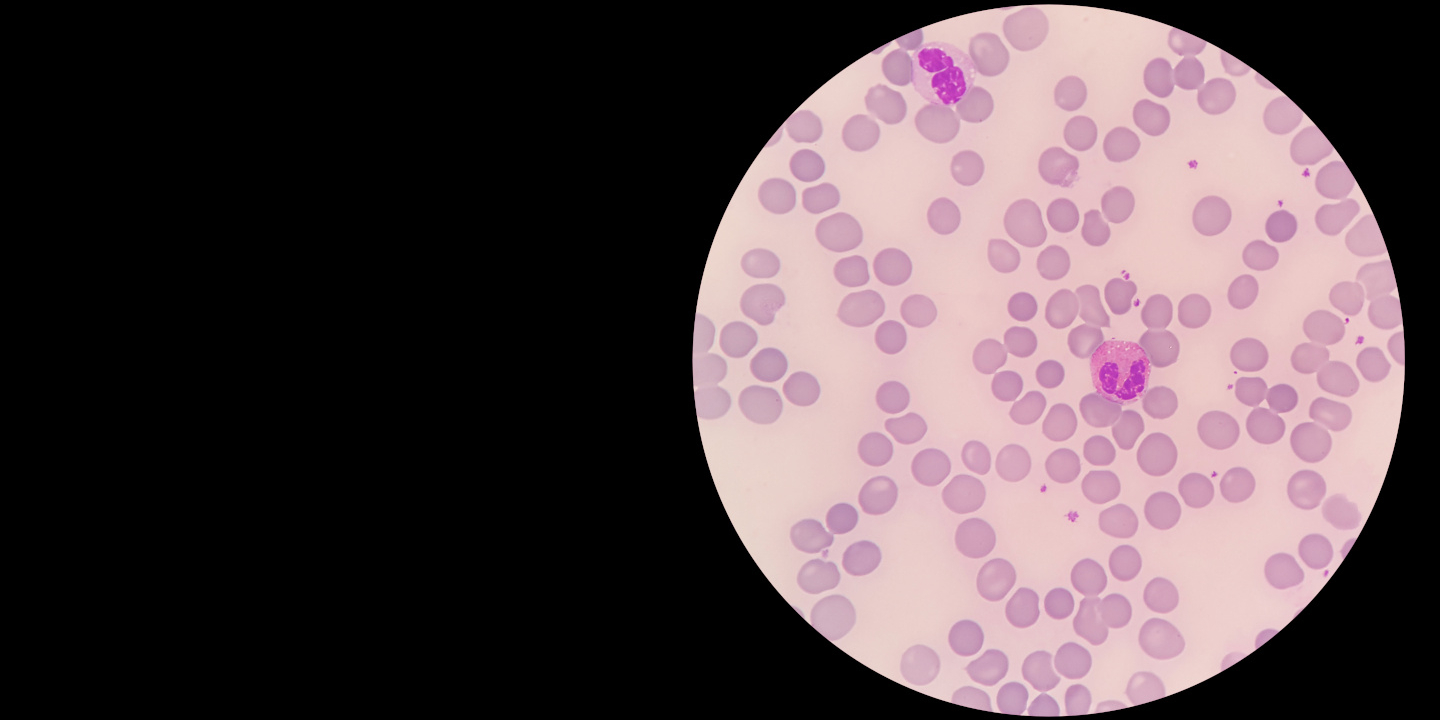
Elephant blood under a microscope

In Memoriam:
- Dr. Soon Hon Cheong, DVM, PhD, DACVT, 1978-2025
Welcome New Faculty:
- Dr. Manuel Fernandez Barrientos, Assistant Clinical Professor, Section of Anesthesiology and Pain Medicine
Congratulations To:
- Dr. Patrick Carney received the 2026 Dr. Alexander de Lahunta Teaching Award. This honor, chosen solely by CVM students, reflects the lasting impression your teaching has made on those you mentor. Your dedication to clinical education, your ability to inspire and connect with students, and your commitment to excellence in the classroom and clinic embody the spirit of “Dr. D” — a legendary educator whose legacy continues to shape veterinary medicine.
- Dr. Romain Pariaut, promoted to Professor in the section of Cardiology
- Dr. Nadine Fiani, promoted to Clinical Professor in the section of Dentistry and Oral Surgery